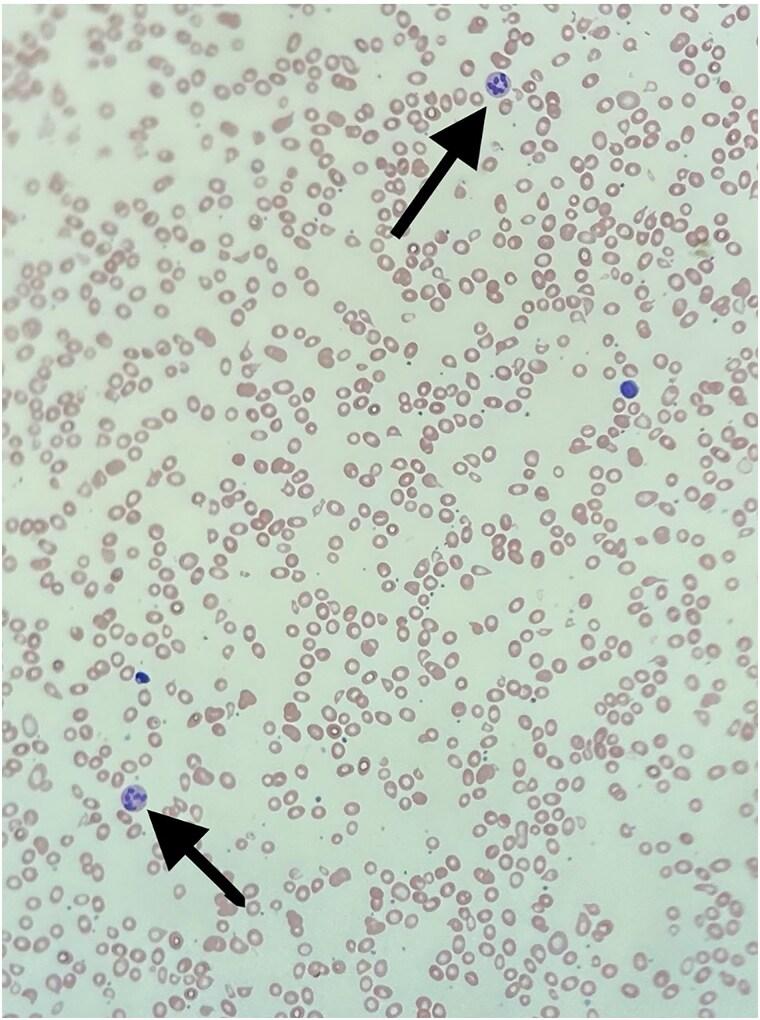
https://cdn.ncbi.nlm.nih.gov/pmc/blobs/e76d/12046220/d548d8980044/luaf090f1.jpg

一名患有自身免疫性多内分泌腺病-念珠菌病-外胚层营养不良的儿科患者的恶性贫血
Pernicious Anemia in a Pediatric Patient With Autoimmune Polyendocrinopathy-Candidiasis-Ectodermal Dystrophy.
作者信息
Kokinakos Konstandina, Botwinick Marissa, Weidner Melissa, Drachtman Richard
机构信息
Department of Pediatrics, Rutgers, Robert Wood Johnson Medical School, New Brunswick, NJ 08901, USA.
Department of Pediatric Hematology and Oncology, Rutgers Cancer Institute of New Jersey, New Brunswick, NJ 08901, USA.
出版信息
JCEM Case Rep. 2025 May 2;3(6):luaf090. doi: 10.1210/jcemcr/luaf090. eCollection 2025 Jun.
Autoimmune polyendocrinopathy-candidiasis-ectodermal dystrophy (APECED) is an autosomal recessive disease caused by a monogenic pathogenic mutation in the autoimmune regulator () gene. is a transcriptional regulatory gene expressed within thymic medullary cells, which play a critical role in developing central immune tolerance. APECED is classically associated with the triad of chronic mucocutaneous candidiasis, hypoparathyroidism, and adrenal insufficiency. We report a case of a pediatric patient with a known history of APECED who presented with symptomatic megaloblastic anemia and was found to have vitamin B12 deficiency secondary to the presence of antibodies to intrinsic factors. Interestingly, our patient did not have gastric parietal cell antibodies, which are present in 90% of pernicious anemia cases. Pernicious anemia itself is relatively rare and primarily manifests in the elderly population. There is limited literature involving pernicious anemia within the pediatric population, specifically within the subgroup that has APECED. Screening and early recognition of pernicious anemia in this relatively rare condition is crucial, as it has the potential to be life-threatening if left unaddressed.
自身免疫性多内分泌腺病-念珠菌病-外胚层营养不良(APECED)是一种常染色体隐性疾病,由自身免疫调节因子(AIRE)基因的单基因致病性突变引起。AIRE是一种在胸腺髓质细胞中表达的转录调节基因,在中枢免疫耐受的形成中起关键作用。APECED典型地与慢性黏膜皮肤念珠菌病、甲状旁腺功能减退和肾上腺功能不全三联征相关。我们报告一例有APECED病史的儿科患者,该患者出现有症状的巨幼细胞贫血,经检查发现因存在内因子抗体而继发维生素B12缺乏。有趣的是,我们的患者没有胃壁细胞抗体,而在90%的恶性贫血病例中存在该抗体。恶性贫血本身相对罕见,主要在老年人群中出现。关于儿科人群中,特别是患有APECED的亚组中的恶性贫血的文献有限。在这种相对罕见的疾病中筛查和早期识别恶性贫血至关重要,因为如果不加以处理,它有可能危及生命。